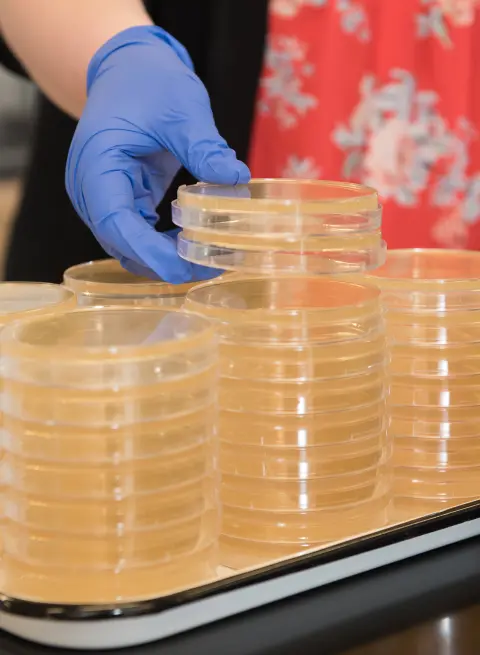
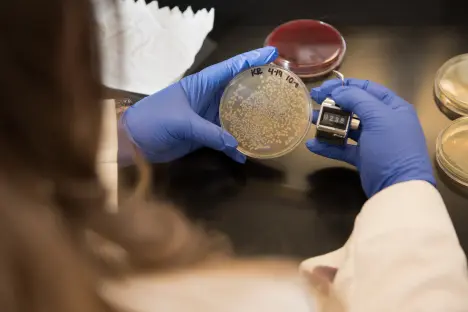

Medical Laboratory Science Program Overview
This optional concentration for biology majors will provide you with a strong background in the basic sciences and give you the clinical preparation you need to gain certification for a career in medical laboratory science. Medical laboratory scientists are healthcare professionals who collect and analyze bodily fluids, tissues and other samples from patients, either in a hospital setting or a clinical laboratory.
Note that in this concentration, your fourth year of study takes place at a hospital-based, NAACLS-certified clinical program partner. However, if at that point you would rather continue at AU, you can choose to remain a biology major.

Is a Career in Medical Laboratory Science Right for You?
This concentration is ideal for anyone who:
- Is interested in a medical or health profession without waiting years for the education and clinical training that is often needed in those fields.
- Aims to learn about acquiring and analyzing biological specimens.
Learning Experiences
When you choose a concentration in medical laboratory science, you can look forward to taking the same basic science courses as other AU Biology majors and clinical courses that are taught to standards set by the National Accrediting Agency for Clinical Laboratory Sciences.

Sample Curriculum
The curriculum includes six semesters (three years) of coursework at Ashland University and a fourth year at a hospital-based, NAACLS-certified clinical program partner. Students must apply for the fourth year at each partner program and are not guaranteed admission, but our program is designed to give students the background that is required for admission.
Learn more about the Medical Laboratory Sciences curriculum by reviewing the Four-Year Curriculum Guide and Academic Catalog.
Other related programs include the Biology and Forensic Biology programs.
First Year
Second Year
Third Year
Fourth Year
Scholarships

Ashland University has been awarded a grant from the state of Ohio to provide Choose Ohio First Scholarships to outstanding students with interests in the natural and physical sciences. These scholarships support academically strong students who plan to continue to graduate school, health-related professional programs or employment in STEM industries after completing a bachelor’s degree.
AU Dean's Scholarship
The Dean's Scholarship was created to enhance the undergraduate academic experience for new first-time and transfer students enrolled in a major within the College of Arts & Sciences. It is a merit-based, renewable scholarship that can be "stacked" on top of other awarded AU academic scholarships. In addition, students have the opportunity to participate in unique academic communities with a focus on career coaching and preparation.
Ohio EPA Scholarship
These merit based, nonrenewable scholarships will be given to undergraduate students enrolled at an Ohio public or private college/university who can demonstrate their knowledge and commitment to careers in environmental sciences or environmental engineering. Students must be entering their Junior or Senior year. Awardees will be selected by the Academy appointed panel.
Graduate Outcomes
Students who graduate from our Medical Laboratory Science program may elect independently to take an exam for Medical Laboratory Science licensure through the National Accrediting Agency for Clinical Laboratory Sciences (NAACLS) rather than having to wait several years to gain the necessary experience to be ready for it.

Career Opportunities
According to the U.S. Bureau of Labor Statistics, positions in Medical Laboratory Science fields are expected to grow by five percent from 2023 to 2033, which is faster than average. In 2023, the median annual pay for professionals licensed to work in this field was $60,780.
